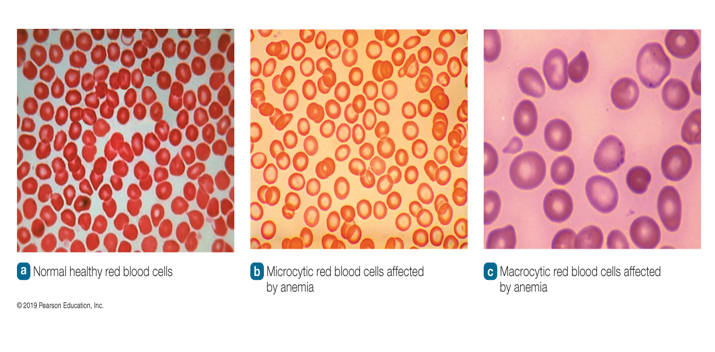
<p>Macrocytic Anemia</p>

Nutrition Chapter 13 (Exam 3)
1/25
There's no tags or description
Looks like no tags are added yet.
Name | Mastery | Learn | Test | Matching | Spaced | Call with Kai |
|---|
No analytics yet
Send a link to your students to track their progress
26 Terms
Trace minerals what are they and their functions?
Iron
Zinc
Iodine
Fluoride
Less than 5gram of trace minerals are in the body
Daily dietary needs are less than 20milligram
Amount in plants depends on the amount contained in the soil in which the plant was grown
Found in whole grains, legumes dairy, meat, and seafood
Processing removes trace minerals found in the bran and germ of grains
Stable in cooking
Bioavailability of trace minerals can vary according to:
Individual nutritional status
Other foods eaten
Form of the mineral
Presence of other minerals (compete with others for absorption-same ionic charge)
Some are recycled in the body and can be used repeatedly, such as iron
Most trace minerals function as cofactors
Form part of an enzyme complex
Metalloenzymes: Active enzymes that contain one or more metal ions that are essential for their biological activity
Iron, copper, and selenium (cofactors within antioxidant enzyme systems)

Metalloenzymes
Active enzymes that contain one or more metal ions that are essential for their biological activity
What is Fluoride
Is not classified as essential because the body does not require it for normal growth and development
Is found naturally in plants and animals, and often added to water supply
Is mostly absorbed in the small intestine
Metabolic Functions of Fluroide
Develops and maintains strong healthy teeth
Forms fluoroapatite which helps harden the outer layer of the tooth (the enamel) and makes the tooth more resistant to damage (tooth decay)
___from food, beverages, and toothpaste repairs eroded enamel
Inhibits the interaction between bacteria and carbohydrate, thereby reducing acid production
____in saliva helps remineralize the hydroxyapatite structure of the tooth
Helps maintain strong bones
Combined with calcium and vitamin D
Increases bone mineral density
Reduces the incidence of osteoporosis

Food Sources of Fluoride
Best source is fluoridated water and beverages and foods made with fluoridated water
Faucet water is best
Some, but not all, bottled water contains fluoride
Tea (particularly decaffeinated tea)
Tea leaves accumulate fluoride
Fluoride Toxicity and Deficiency
Toxicity
Fluorosis in teeth and bones
Condition caused by excess amounts of fluoride, resulting in mottling of the teeth
Deficiency
Increased susceptibility to dental caries


What is Zinc?
Found in very small amounts in almost every cell of the body
Mostly in bone and muscle
Involved in the function of more than 100 metalloenzymes, including those used for protein synthesis
Absorption is reduced when:
High levels of nonheme iron are present
Phytates and diets high in fiber are consumed
Consuming animal proteins improves zinc absorption
Helps wounds heal
Needed for DNA and RNA synthesis
Turns genes on and off
Keeps the immune system healthy
May reduce duration of the common cold
Acts as an antioxidant
Reduces inflammation
Part of enzymes and proteins that repair skin cells and enhance their proliferation
Improves taste perception
May prevent age-related macular degeneration
Zinc Toxicity
Toxicity
Symptoms: Stomach pain, nausea, vomiting, and diarrhea
Excess can:
Interfere with copper absorption
Suppress the immune system
Lower HDL cholesterol
Zinc Deficiency
Deficiency
Delayed growth in children
Hair loss
Loss of appetite
Impaired taste of food
Diarrhea
Delayed sexual maturation
Impotence
Skin rash
What is Iodine?
Iodide (I-), the ionic form of iodine, is an essential mineral
Mandatory salt iodization significantly reduced the incidence of goiter in the United States

Metabolic Functions of Iodine
Component of the thyroid hormones
Thyroid gland traps iodine and uses it to make the thyroid hormones thyroxine (T4) and triiodothyronine (T3)
Thyroid hormones help regulate:
Metabolic rate
Reproduction
Energy (ATP) production in the TCA cycle
Nerve, muscle, and heart function


Iodine Toxicity and Deficiency
Toxicity
Impairs thyroid function and reduces the synthesis and release of thyroxine
Deficiency:
Simple goiter: Enlarged thyroid gland
Secondary deficiency and goiter
Goitrogens: Substances in food that reduce the use of iodine by the thyroid gland, resulting in goiter
Rutabagas, cabbage, soybeans, and peanuts
During pregnancy
Damage to brain of the developing baby
Cretinism (congenital hypothyroidism)
Severe deficiency
Abnormal sexual development
Mental retardation
Dwarfism

Heme Iron
Part of:
Hemoglobin (in red blood cells)
Myoglobin (in muscle cells)
Cytochromes (in electron transport chain)
Found in animal foods
Meat, poultry, fish
Reduced form-Ferrous iron (Fe+2)
More easily absorbed
Nonheme Iron
Found in plant foods
Grains, vegetables, enriched breads, and fortified cereals
80% of iron consumed in foods (100% for vegans)
Oxidized form-Ferric iron (Fe+3)
Iron Bioavailability (Heme Iron and Nonheme Iron)
Heme Iron → animal foods
Nonheme Iron → plant foods
The bioavailability of iron is influenced by several factors
The molecular form of the iron, iron status of the individual, and the types of food eaten at the same time
Heme iron is two to three times more bioavailable than nonheme iron
Iron is absorbed in the enterocyte and attached to ferritin in the enterocytes (Figure 13.1)
Nonheme Iron Absorption
Enhance ___ Iron Absorption
Sufficient hydrochloric acid in the stomach
The form of iron in the food; heme iron is more easily absorbed than nonheme iron
Increased need for iron (blood loss, pregnancy, growth)
Vitamin C in the small intestine at the same time
Presence of MFP factor (meat, fish, poultry)
Decrease Iron Absorption
Phytates in cereal grains (dietary fiber)
Oxalates
Polyphenols (tea or coffee)
Reduced hydrochloric acid in stomach
Excess use of antacids
Excess minerals such as calcium, zinc, and magnesium

Iron Absorption and Transport
Hormonal regulation of iron absorption
Hepcidin: Hormone that controls iron absorption and transport
High iron stores:
When the body has high levels of iron stored, it signals to the liver that no more iron is needed in the blood
liver produces more hepcidin to inhibit ferroportin from transporting iron out of the enterocyte into the portal blood
Low iron stores:
When the body has low levels of iron stores, it signals to the liver that more iron is needed in the blood
Hepcidin levels are decreased
Stored iron affects iron absorption
Low iron stores increase intestinal iron absorption
Less ferritin (protein that stores iron) is produced
more iron will be absorbed directly into the bloodstream
High iron stores decrease intestinal iron absorption
More ferritin and hepcidin are produced
Block iron from absorption and to store the iron in the enterocytes
Excess iron is excreted in the feces

Iron Homeostasis
Body does not need iron
Iron is stored in the ferric form (Fe3+; oxidized form) and binds itself to ferritin (protein that stores iron) or hemosiderin (protein that stores additional iron)
Body needs iron
Iron is released from the ferritin and transported into the portal vein. Then, the iron attaches itself to transferrin, a protein carrier which transports iron throughout the body

Metabolic Functions of Iron
Participates in oxidation-reduction reactions
Also referred to as redox reaction (transfer of electrons)
Example; Fe+2 ↔ Fe+3 +e-
(Fe2→ reduced form)
(Fe3→ oxidized form)
Major component of hemoglobin and myoglobin
Transports oxygen and carbon dioxide
Participates in energy metabolism
Performs as a cofactor in enzymes in energy metabolism
Part of cytochromes in the mitochondria
Immune function
Needed to produce lymphocytes and macrophages
Protects cell membranes from free radical damage
Needed for brain function
Helps enzymes involved in the production of neurotransmitters
Dopamine, epinephrine, norepinephrine, and serotonin
Deficiency during the early years of childhood is associated with decreased cognitive ability during the later school years.

Iron Toxicity
Symptoms include constipation, nausea, vomiting, and diarrhea
__ poisoning in children
Accidental consumption of supplements containing iron is the leading cause of poisoning deaths in children under age 6
More likely to occur with supplementation or in individuals with the genetic disorder hemochromatosis
___overload
Buildup of excess stores of iron over several years
Can damage organs and tissues
Hemochromatosis can cause overload
A genetic disorder in which individuals absorb too much dietary iron
Iron Deficiency and interactions with other nutrients
___-deficiency anemia
Hemoglobin levels decrease
Oxygen delivery to tissues diminished
Symptoms include fatigue, weakness, reduced ability to fight infection.
Populations at risk
Pregnant women
Menstruating women and teenage girls (especially those with heavy blood losses)
Preterm or low birth weight infants
Older infants and toddlers
Interactions with other nutrients: zinc, calcium, ascorbic acid
What are Nutrient Deficient Anemias?
Anemias
Blood lacks enough healthy, normal-sized red blood cells to deliver oxygen to the tissues.
Classified by the size of red blood cells
Most anemias are caused by nonnutritional factors
Losing too much blood
Insufficient red blood cell production
Red blood cells being destroyed
Other causes
Low nutrient intake
Malabsorption
Abnormal metabolism of nutrients

Microcytic Anemia
Small red blood cells that lack color
Lacks hemoglobin
Most common cause
Iron deficiency
Other causes
Vitamin B6 deficiency
Macrocytic Anemia
Fewer, abnormally large red blood cells
Lacks sufficient hemoglobin
Most common cause
Folate or vitamin B12 deficiency
Other causes
Pernicious anemia (inability to absorb vitamin B12)
Microcytic/ Iron Deficiency Anemia
Iron-deficiency anemia is the most common type of microcytic anemia and occurs when there is insufficient iron in the body
Women are at a higher risk than men
In men and postmenopausal women:
Occurs due to blood losses from ulcers, excess aspirin use, specific cancers
Signs and symptoms
Fatigue, pale skin color, irritability, shortness of breath, sore tongue, brittle nails, pica, headache in the frontal lobe, blue tinge to the whites of the eyes, decreased appetite
Children can develop irreversible intellectual impairment
Testing for iron-deficiency anemia involves simple blood tests.
Complete blood count or total iron-binding capacity
Treatment for iron-deficiency anemia
Iron supplements are needed
Ferrous sulfate, ferrous gluconate, or ferrous fumarate are most easily absorbed
Take iron with orange juice or other vitamin C source
Avoid taking with milk or antacids
Macrocytic/ Pernicious Anemia
A form of ____ anemia caused by the body's inability to absorb vitamin B12
Cause:
Typically, a lack of intrinsic factor due to gastritis or an autoimmune reaction that attacks the parietal cells of the stomach
Symptoms:
Diarrhea or constipation, pale skin, problems concentrating, shortness of breath
Treatment:
Intramuscular injections of vitamin B12